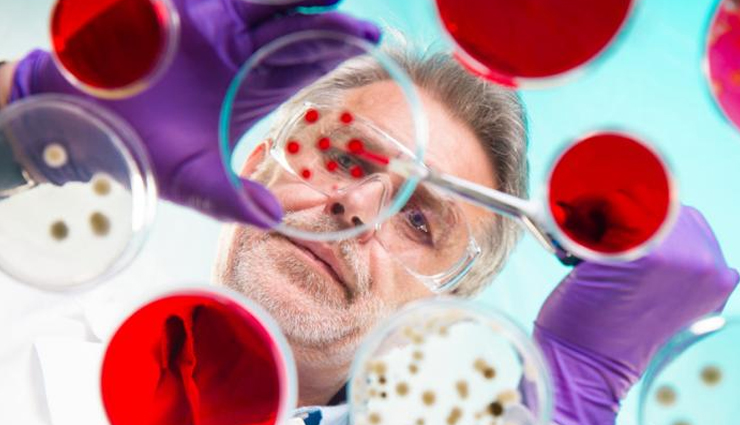
clove oil for kids,health benefits of clove oil,Health tips,fitness tips

- Home›
- Healthy Living›
- 5 Amazing Benefits Of Clove Oil For Kids
5 Amazing Benefits Of Clove Oil For Kids
By: Kratika Maheshwari Tue, 10 May 2022 12:44:01

Health benefits offered by clove oil for kids include its use for curing infections, antiviral properties, has antioxidant properties, can be used as a pain killer, possesses antioxidant properties, can strengthen the immune system, can protect against respiratory issues and can act as an insect repellent.
Cloves are one of the popular spices from South East Asian countries such as India, Indonesia, Pakistan and Sri Lanka and African countries such as Madagascar and Tanzania. The flower buds from clove plant are dried and used as spice in various cuisines including Asian, African and Middle Eastern. The scientific name of clove is Syzygium aromaticum.
For a very long time, clove has also been used in several ancient medicinal schools of thought including Traditional Chinese Medicine, Ayurveda in India. It has been used and is still being used as a pain killer, carminative drug, anthelmintic, for kidney ailments, spleen and stomach meridians, etc.
# Can be used for curing infections
Clove oil has antibacterial and antifungal properties. These are highly useful in killing infections causing bacteria and fungi on the body. Wounds can be the places for these infections causing bacteria and fungi to enter into the body. Hence, applying a bit of clove oil on wounds can be very beneficial in controlling infections.

# Has antiviral properties
Clove oil also possesses antiviral properties, apart from antibacterial and antifungal properties. Studies have shown that clove oil can actually stop the DNA synthesis of viruses with its biochemicals.

# Is a potent antioxidant
Clove oil contains good amount of antioxidants. Studies indicate that spices are the richest source of antioxidants and clove is not an exception. Clove oil with this high antioxidants is ideal for reducing free radical activity in the body and keeping it hale and healthy.

# Possesses pain killer properties
For many centuries, clove has been used a painkiller. Clove oil is highly effective in treating various pains in the body including toothache.

# Provides good dental care
Clove oil has also been used in India for good dental health. With its antibacterial properties, clove oil not only provides relief from toothache, it is also helpful in controlling sore gums, mouth ulcers and teeth cavities as well. Not only clove oil, but clove helps control bad breath. And that’s why in ancient India, it was customary to meet any king or higher officials after chewing a clove.





